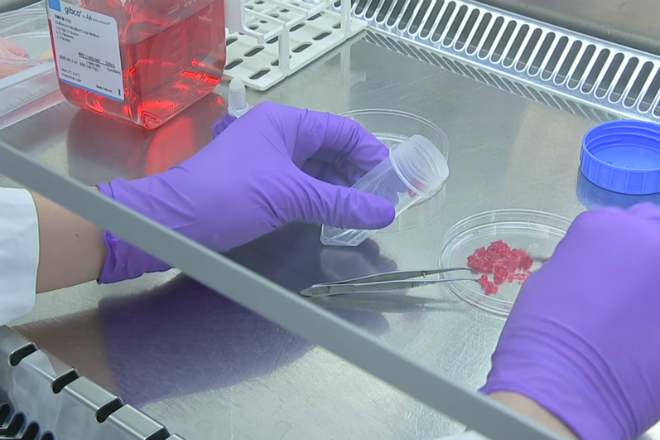

Искусственное мясо будущего: что вскоре придется есть нам всем
Каждый год уровень потребления мяса по миру растет. Если сейчас мы еще как-то справляемся с производством, то в будущем нам всем прийдется перейти на искусственно изготовленный продукт: вот, как он выглядит и что из себя представляет.

Проблема в том, что мы не можем выращивать больше коров, так как рискуем окончательно уничтожить экологию планеты. Во многих странах скот вырабатывает больше парниковых газов, чем все автомобили и ТЭЦ вместе взятые. Наращивать поголовье скота — не выход.

И поэтому промышленные магнаты вместе с правительством плотно занимаются созданием искусственного мяса. Впервые образцы были продемонстрированы в 2013 году, правда производство его стоило огромных денег.
Искусственное мясо выращивают в чашках Петри и специальных контейнерах. Ученые собирают клетки животных, склонные к быстрому размножению. Насыщенный протеином раствор помещают в биореактор, где созданы все условия для роста. Можно сказать, что сами клетки и не подозревают, что растут вне тела живого существа.
Эксперты полагают, что в течение ближайших 25 лет на искусственное мясо перейдет вся планета. И ничего плохого в этом нет: по сути, это и есть настоящее мясо, просто выращенное в пробирке.

